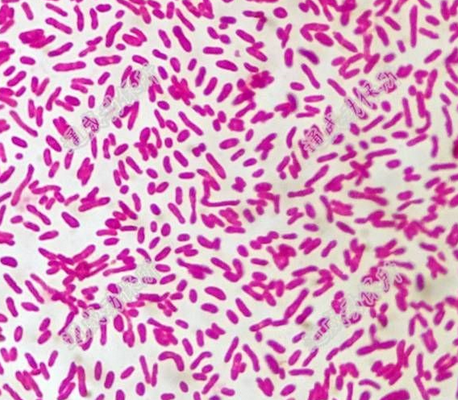
革兰氏阴性杆菌

革兰氏染色阴性

革兰氏阴性菌
图片尺寸1124x930
白色背景为红色革兰氏阴性杆菌.
图片尺寸1100x1100
实验-革兰氏染色法
图片尺寸964x602
通过革兰氏染色,几乎可以把所有的细菌分成
图片尺寸375x268
革兰氏染色,革兰氏阴性杆菌.
图片尺寸1200x803
阴性菌泛指 a target="_blank" href="/item/革兰氏染色反应/3211029"
图片尺寸733x702
革兰氏阴性杆菌
图片尺寸458x400
革兰氏阴性细菌(2)革兰氏染色反应呈红色(复染颜色)的细菌称为革兰氏
图片尺寸436x291
副溶血弧菌革兰氏染色阴性,杆状,球杆状,弧状,球状#显微镜 - 抖音
图片尺寸1920x1440
革兰氏阴性双球菌
图片尺寸1280x1706
兽医图片大全革兰氏阴性菌红色
图片尺寸600x448
革兰氏阴性细菌血流感染
图片尺寸1100x1100
氏染色,油镜下可见大量多核粒细胞,并且在细胞内外可见大量的革兰阴性
图片尺寸660x660
土法革兰氏染色之阴性杆菌vs阳性球菌,求鉴定
图片尺寸3200x2400
革兰阴性球杆菌,多数成对或短链排列.
图片尺寸4480x2520
革兰阴性菌的讨论
图片尺寸640x480
此显微照片揭示了革兰氏阴性菌,奈瑟subflava的存在.
图片尺寸1200x791
p> a target="_blank" href="/item/革兰氏染色法/712790" data
图片尺寸140x102
这是革兰氏阴性杆菌吗?(从品红亚硫酸钠培养基上挑的可疑菌落镜检的)
图片尺寸752x1000
阴性菌泛指 a target="_blank" href="/item/革兰氏染色反应/3211029"
图片尺寸1018x663

.gif)







